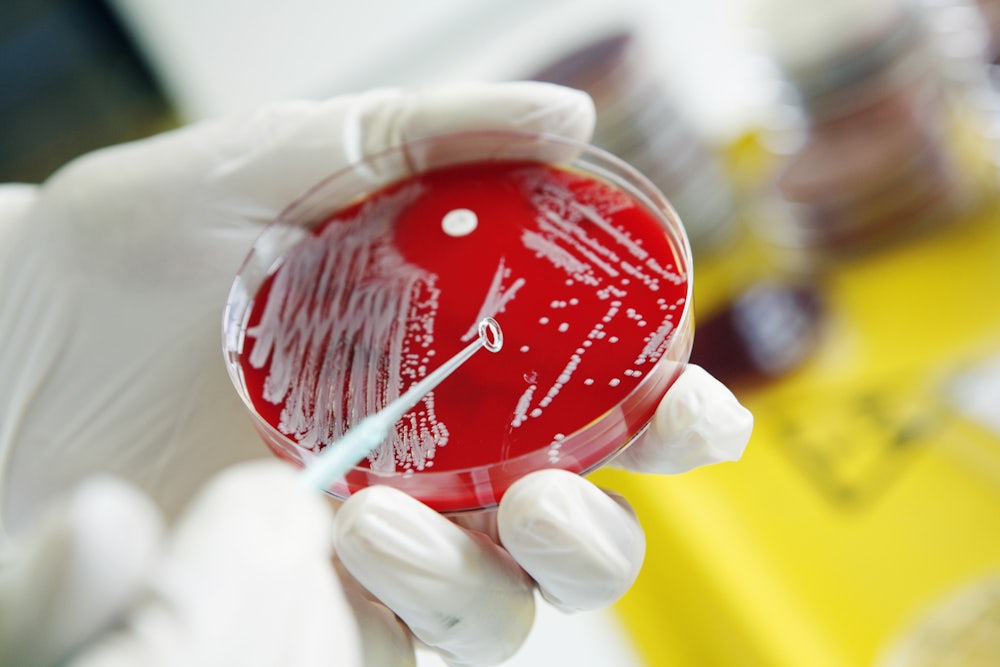

The evangelical right is always waiting for the Apocalypse, counting the days, charting signs and wonders, making calculations as to the time and hour of the end times. One would think that in 2020, when the world was faced with a global catastrophe and a complete breakdown in the normal order of things, they would seize on Covid-19 as a sure sign that those days had come. But for the most part, they chose to deny rather than embrace the coronavirus: Their president and their pastors downplayed its severity and its impact, claimed numbers of deaths were exaggerated, and ridiculed those taking it seriously. Rather than embrace the end of days, they demanded a return to the way things were.
Perhaps this has to do with the realization that many of us faced in those early months of 2020: that we were suddenly and radically living on the virus’s terms, not our own. Instead of a grand battle of good and evil with humans at the center of the action, we were obligated to learn and adapt our behavior to a nonhuman organism whose motives and purpose were incomprehensible to us. How was it possible, in such an ordeal, to maintain the supposed truth of Genesis 1:26, that God intended humanity to have dominion over livestock and all of nature? Perhaps the coronavirus had dominion over us, and we were the livestock?

Jonathan Kennedy’s Pathogenesis: A History of the World in Eight Plagues takes this idea as its inspiration, asking us to rethink our relationship to the bacteria and viruses that drive pandemics. Perhaps, Kennedy suggests, we are not the grand protagonists to our story; perhaps we are just bit players in a larger drama. He retells the story of human civilization from its earliest prehistoric roots to the current decade, not from the perspective of its Great Men so much as its Great Diseases—the bacteria and viruses that have dogged us since Homo sapiens emerged as a species. For Kennedy, it is smallpox, yellow fever, and malaria that matter far more than Charlemagne, Cortes, or Napoleon; he argues not only that “humans have a far less significant place in the world than we used to think” but also that “microbes play a much more important role than we would have believed just a few years ago.”
Quoting Stephen Jay Gould, who wrote that “on any possible, reasonable, or fair criterion, bacteria are—and always have been—the dominant form of life on earth,” Kennedy argues that we are as much a product of disease as we are of any conscious decisions. “Outbreaks of infectious diseases have destroyed millions of lives and decimated whole civilizations,” he writes in his introduction, “but the devastation has created opportunities for new societies and ideas to emerge and thrive. In this way, pathogens have been the protagonists in many of the most important social, political, and economic transformations in history.” A radical thought: What if we, for all our hopes, dreams, and best laid plans, are nothing more than the raw material used by bacteria and viruses to shape the world in their image?
Kennedy lays this argument out through reframing well-known historical events in terms of the diseases and epidemics that led to them. The rise and fall of empires, the brutal conquests of colonial powers, the map as we now know it—all this has depended far more on disease than we may have thought. Some of this may sound familiar: for example, the fact that European settlers in North America, both intentionally and unintentionally, used smallpox to wipe out Indigenous populations, to make the work of colonizing easier. Entirely new to North America, smallpox “raced ahead of the Spanish,” in Kennedy’s words, devastating whole communities. The disease proved decisive: “Without the help of Old World pathogens,” he argues, “early efforts to colonize the American mainland foundered.” Take, for example, the Spanish conquistadors’ attempts to take Tenochtitlan. The first try failed, but a second expeditionary force arriving a year later brought with it smallpox, which devastated the city and brought the Spanish victory.
More subtle was the arrival of the Puritans and the settlement of Plymouth Colony. Earlier attempts to build colonies in New England had faced fierce resistance from the Indigenous peoples already living there. The Popham Colony in southern Maine failed after 14 months; the French trading post near Cape Cod also fell to Native attacks. But these earlier attempts laid the groundwork for the Puritans by spreading disease; when the Pilgrims got there, they found abandoned villages with grain and beans that they used to get through their first winter, the remnants of Native communities destroyed by smallpox. While these Europeans claimed this food as “God’s good providence,” Kennedy suggests instead that “their gratitude at Thanksgiving should be directed to the Old World pathogens that made the settlement of Plymouth Colony possible.” The rest, unfortunately, is history—crucially, in Kennedy’s version of events, the real colonizer of the Americas was the variola virus, with the Spanish and English as merely its unwitting hosts.
Other examples that Kennedy invokes may be more surprising. Despite the Roman Empire’s vaunted aqueduct and sewer systems, he explains, Romans’ lack of any understanding of germ theory meant that their water infrastructure festered with disease, hastening the empire’s downfall. Citing Kyle Harper’s The Fate of Rome, Kennedy argues that “pandemics caused immense damage and played a crucial role in weakening the Roman Empire,” far more so, he claims, than the “Barbarians” at the gates.
Pathogenesis also convincingly argues that the birth of the nation of Haiti, and perhaps even the rise of the United States in its current shape, can be traced to yellow fever and the humble mosquito, Aedes aegypti, its primary host. In 1802, about a decade after the outbreak of the Haitian Revolution, Napoleon sent an expeditionary force of some 30,000 troops to its former colony Saint-Domingue, hoping to retake the land and reimpose slavery. The freed Haitians, however, defeated them not with military might but with disease. As the rebels’ commander, Jean-Jacques Dessalines, told his troops in March 1802, “The whites from France cannot hold out against us here in Saint-Domingue. They will fight well at first, but soon they will fall sick and die like flies.” Dessalines’s army used the island’s yellow fever against the invading French: It avoided a straightforward conflict when Napoleon’s troops first arrived in spring, drawing them into a quagmire that lasted until summer, when the rains came. With the rains came standing water, the perfect breeding ground for Aedes aegypti, the mosquito that carried yellow fever and proved a crucial ally against the French. According to one historian’s estimate, of the 65,000 French soldiers sent to recapture the colony, more than 50,000 died, overwhelmingly from yellow fever.
Unable to maintain their Caribbean outpost, the French ultimately sold the sprawling Louisiana territory to the United States; a fact that leads to Kennedy’s conclusion that the U.S. as it exists today owes a great debt of gratitude to Haiti’s mosquito population.
Again and again, Pathogenesis suggests that the course of history has less to do with our own volition and more to do with the ways in which different diseases fared in different climates. In places where Europeans were less susceptible to disease, such as North America, colonizers brought families and established settlements that eventually became wealthy democracies. In places were Europeans were more susceptible to pathogens, such as sub-Saharan Africa, they built rapacious, extractive industries meant to maximize profit with minimal exposure to the environment, men plundering all they could before returning to their families in Europe healthy and wealthy. What they left behind were landscapes ripped of natural resources and countries that, decades later, still struggle to achieve any kind of remote economic parity with former colonial powers.
At times, the thesis seems stretched a little thin—Kennedy argues that the rise of Christianity over Roman pagan religions can be traced to its version of the afterlife, an afterlife that became attractive in the face of repeated plagues and pandemics. But it would seem that if the issue here is simply mortality, the Roman Empire’s ceaseless warfare might drive soldiers into embracing Christianity’s afterlife as well. At other times, Kennedy’s desire to offer pandemics as the key behind all of human history means Pathogenesis can veer into the same territory as the kinds of books he critiques—Yuval Noah Harari’s Sapiens and Stephen Pinker’s Enlightenment Now: The Case for Reason, Science, Humanism, and Progress, among them—books that offer “this one weird trick” to explain all of human history.
But this quibble doesn’t detract from the main idea that drives Pathogenesis. What the book reveals is the plain fact that humans are often not the only actors on the great stage of history that we assume we are, and that we may not even be the most important. We have used and been used by diseases so repeatedly that, by the end of Kennedy’s book, one begins to wonder if we may exist primarily to spread and promulgate microscopic organisms and viruses. And if that isn’t our main purpose, it certainly remains something we are exceedingly good at—a true calling, you could say.
Our diseases, ourselves. For pathogens need us as much as we need them; the story here is of the interdependence of us and the microbes inside us. Rather than showing how insignificant humans are in the grand scheme of the universe, the true effect of Kennedy’s Pathogenesis may be to invite us to further rethink our long held binary that attempts to separate the human from the rest of the living organisms on this planet.
It also helps to put the last few years in greater context. If one sees human history as more or less constantly engaged in a complicated dynamic with microbes, creating and responding to pandemics, then the Covid-19 outbreak is less of an apocalyptic interruption in the world, heralding the end times, and instead the latest way in which humans have played hosts to yet another player on the world stage.